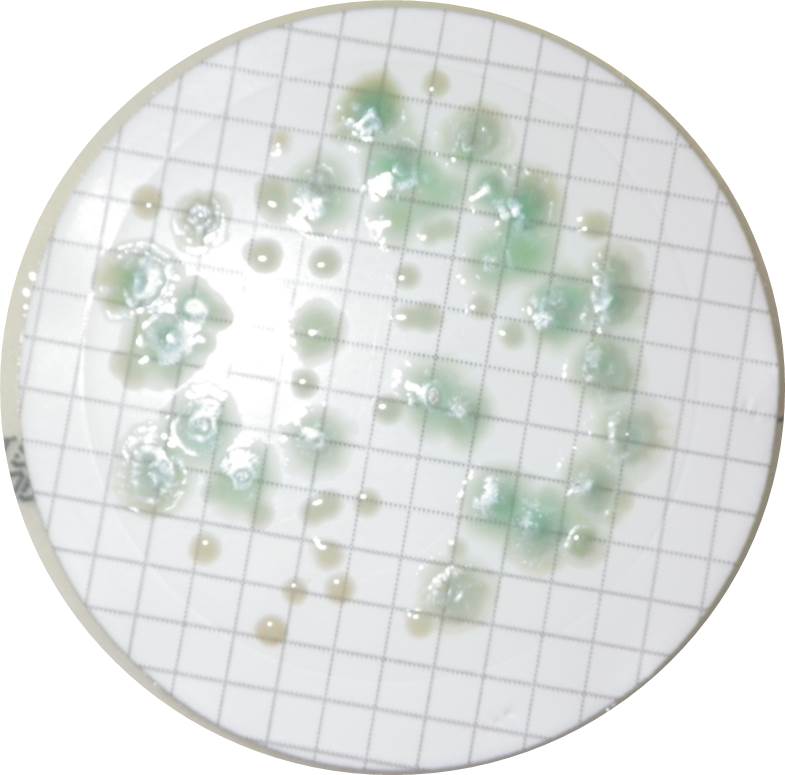

Back to the beginning
Published in Microbiology
A fascinating read (and a challenge for the French skills!) looking back at the original description of Pseudomonas aeruginosa by Carle Gessard, who isolated the bacterium from patient wound dressings that were turning blue and green.
Gessard, C. Sur les colorations bleue et verte des lignes a pansements. Comptes Rendus de l'Académie des Sciences 94, 536-538, (1882)
Isolation of the opportunistic bacterium from tap components has also been reported since 1961 (Wilson, M. G., Nelson, R. C., Phillips, L. H. & Boak, R. A. New source of Pseudomonas aeruginosa in a nursery. JAMA 175, 1146-1148, (1961))
It is certainly interesting to follow the story of problems that still challenge the health system today.
Photograph of P. aeruginosa isolated from tap water.
Please sign in or register for FREE
If you are a registered user on Research Communities by Springer Nature, please sign in